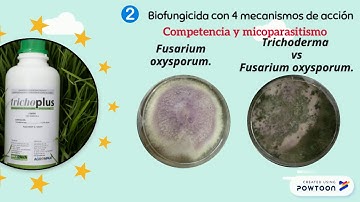
Trichoplus - Trichoderma

⬇ DOWNLOAD NOW
Kalau muncul iklan pop-up, tutup lalu klik tombol kembali
Download lagu Trichoderma Introduction & Function secara gratis hanya untuk keperluan promosi. Dukung artis favorit kamu dengan membeli musik original di iTunes atau platform resmi lainnya.
 How do Trichoderma work? Atens explain it to you
How do Trichoderma work? Atens explain it to you
 Trianum (Trichoderma harzianum) - How does it work?
Trianum (Trichoderma harzianum) - How does it work?
 Trichoderma - A brief over view. Information from a study on trichoderma.
Trichoderma - A brief over view. Information from a study on trichoderma.
 How to Use Trichoderma That You Never Know
How to Use Trichoderma That You Never Know
 Basics of Trichoderma
Basics of Trichoderma
 What Are Mycos? Down To Earth Fertilizers
What Are Mycos? Down To Earth Fertilizers
 Trichoderma harzianum T22 combats Fusarium oxysporum in tomato
Trichoderma harzianum T22 combats Fusarium oxysporum in tomato
Trichoplus - Trichoderma
Trichoplus - Trichoderma